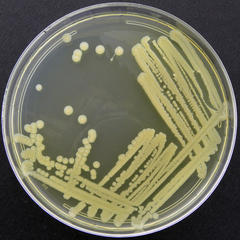
Bacillus megaterium
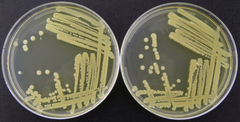
Bacillus megaterium

Bacillus megaterium: taxon details and analytics
- Domain
- Kingdom
- Bacteria
- Phylum
- Firmicutes
- Class
- Bacilli
- Order
- Bacillales
- Family
- Bacillaceae
- Genus
- Bacillus
- Species
- Bacillus megaterium
- Scientific Name
- Bacillus megaterium
Parent Taxon
Sibling Taxa
- Bacillus amyloliquefaciens
- Bacillus anthracis
- Bacillus cereus
- Bacillus circulans
- Bacillus coahuilensis
- Bacillus djibelorensis
- Bacillus fumarioli
- Bacillus fusiformis
- Bacillus granadensis
- Bacillus hwajinpoensis
- Bacillus insolitus
- Bacillus licheniformis
- Bacillus longiquaesitum
- Bacillus megaterium
- Bacillus muralis
- Bacillus mycoides
- Bacillus niameyensis
- Bacillus odysseyi
- Bacillus ohbensis
- Bacillus olivae
- Bacillus paralicheniformis
- Bacillus pseudomegaterium
- Bacillus psychrodurans
- Bacillus psychrotolerans
- Bacillus pumilus
- Bacillus simplex
- Bacillus sphaericus
- Bacillus subtilis
- Bacillus thermoamyloliquefaciens
- Bacillus thuringiensis